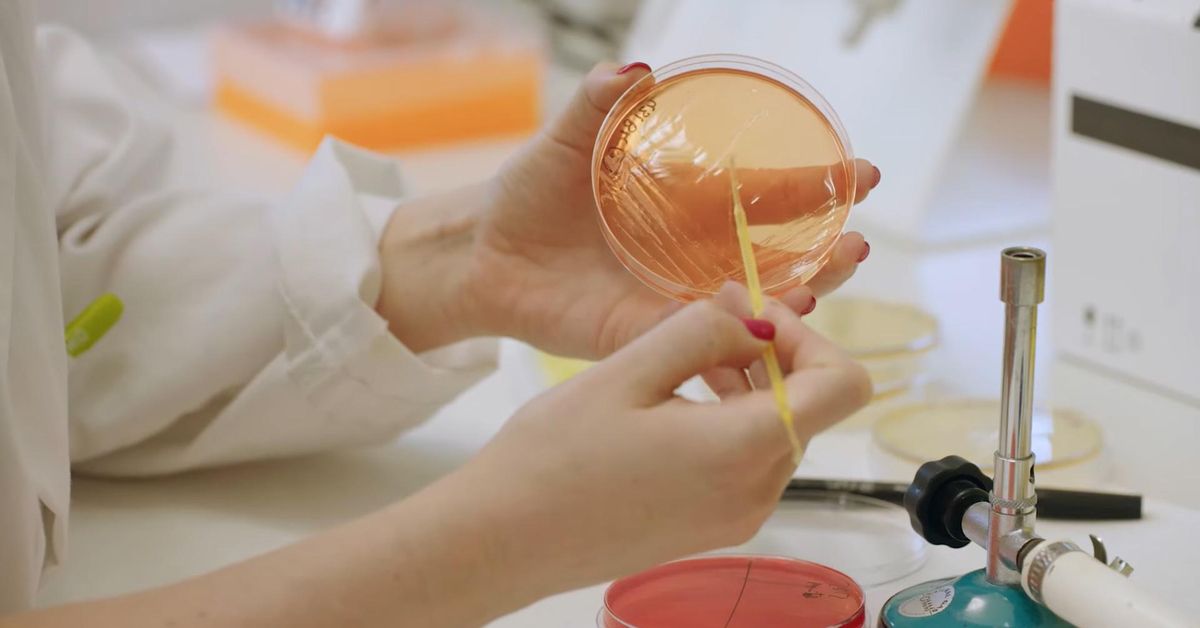

España, un país que desprecia a la ciencia
La ciencia es un florero para los dos principales partidos que han gobernado este país y para unos sindicatos que no se han preocupado nunca por las condiciones laborales del personal científico — La cojera crónica de la ciencia española...
Redirecting to full article...